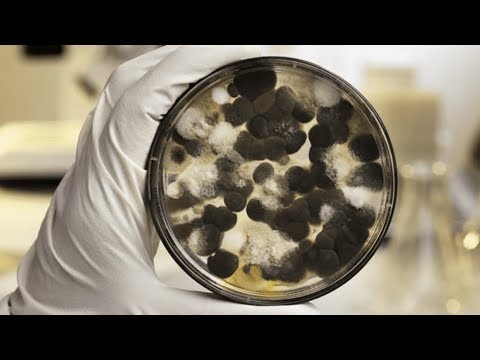

Residential Mold Testing Toronto }}- GTA Restoration is Toronto's #1 Emergency Contractors! Restoring residential & commercial buildings across Toronto & the GTA FAST We Offer 24-Hour ...
Before downloading Residential Mold Testing Toronto Videos , Download mp3 songs all artist or listen music free.
Residential Mold Testing Toronto Free Download Song Mp3 and Mp4 :
Music Discovery, Charts and Song Lyrics : Toronto Water Damage | 416-358-6666 | GTA Restoration | Toronto Mold Removal Toronto Testimonial | Residential Mold Testing Toronto
Toronto Water Damage | 416-358-6666 | GTA Restoration | Toronto Mold Removal Toronto Testimonial - Residential Mold Testing Toronto - GTA Restoration is Toronto's #1 Emergency Contractors! Restoring residential & commercial buildings across Toronto & the GTA FAST We Offer 24-Hour ...
Music Discovery, Charts and Song Lyrics : Mold Removal In Toronto, Ontario | Residential Mold Testing Toronto
Mold Removal in Toronto, Ontario - Residential Mold Testing Toronto - Now more than ever, Toronto property owners are realizing how important it is to improve and maintain their indoor air quality. Mold Busters is dedicated to ...
Music Discovery, Charts and Song Lyrics : Woman Returns To Find Toxic Mould In Toronto! Mold Removal, By GTARestoration.com | Residential Mold Testing Toronto
Woman returns to find toxic mould in Toronto! Mold Removal, by GTARestoration.com - Residential Mold Testing Toronto - A woman returns to find toxic mould in Toronto! Mold Removal, by GTARestoration.com GTA Restoration is Toronto's #1 Emergency Contractors! Restoring ...
Music Discovery, Charts and Song Lyrics : Tagging Along With A Mold Inspection Company | Residential Mold Testing Toronto
Tagging along with a mold inspection company - Residential Mold Testing Toronto - Mold Inspection Sciences shows up to assess the damage of a mold-ridden house.
Music Discovery, Charts and Song Lyrics : TORONTO CITY | Downtown High Rise Emergency Services | Water Damage Toronto Mold Removal | Residential Mold Testing Toronto
TORONTO CITY | Downtown High Rise Emergency Services | Water Damage Toronto Mold Removal - Residential Mold Testing Toronto - TORONTO CITY | Downtown High Rise Buildings 24-Hour Emergency | Fire & Water Damage Restoration! GTA Restoration is Toronto's #1 Emergency ...
Identify the media playing around you Residential Mold Testing Toronto explore the music you love [ Discover song lyrics from your favourite artists TORONTO CITY | Downtown High Rise Emergency Services | Water Damage Toronto Mold Removal, Residential Mold Testing Toronto &] Music Mp3 and Mp4 download that gives you an access to thousand of songs. Download free music, free Mp3, Free Mp4, top charts, playlists, new releases and offline listening.
A mold or mould is a fungus that grows in the form of multicellular filaments called hyphae. This is very annoying. Click here for details on how to remove it. Certified Mold inspections
ReplyDelete